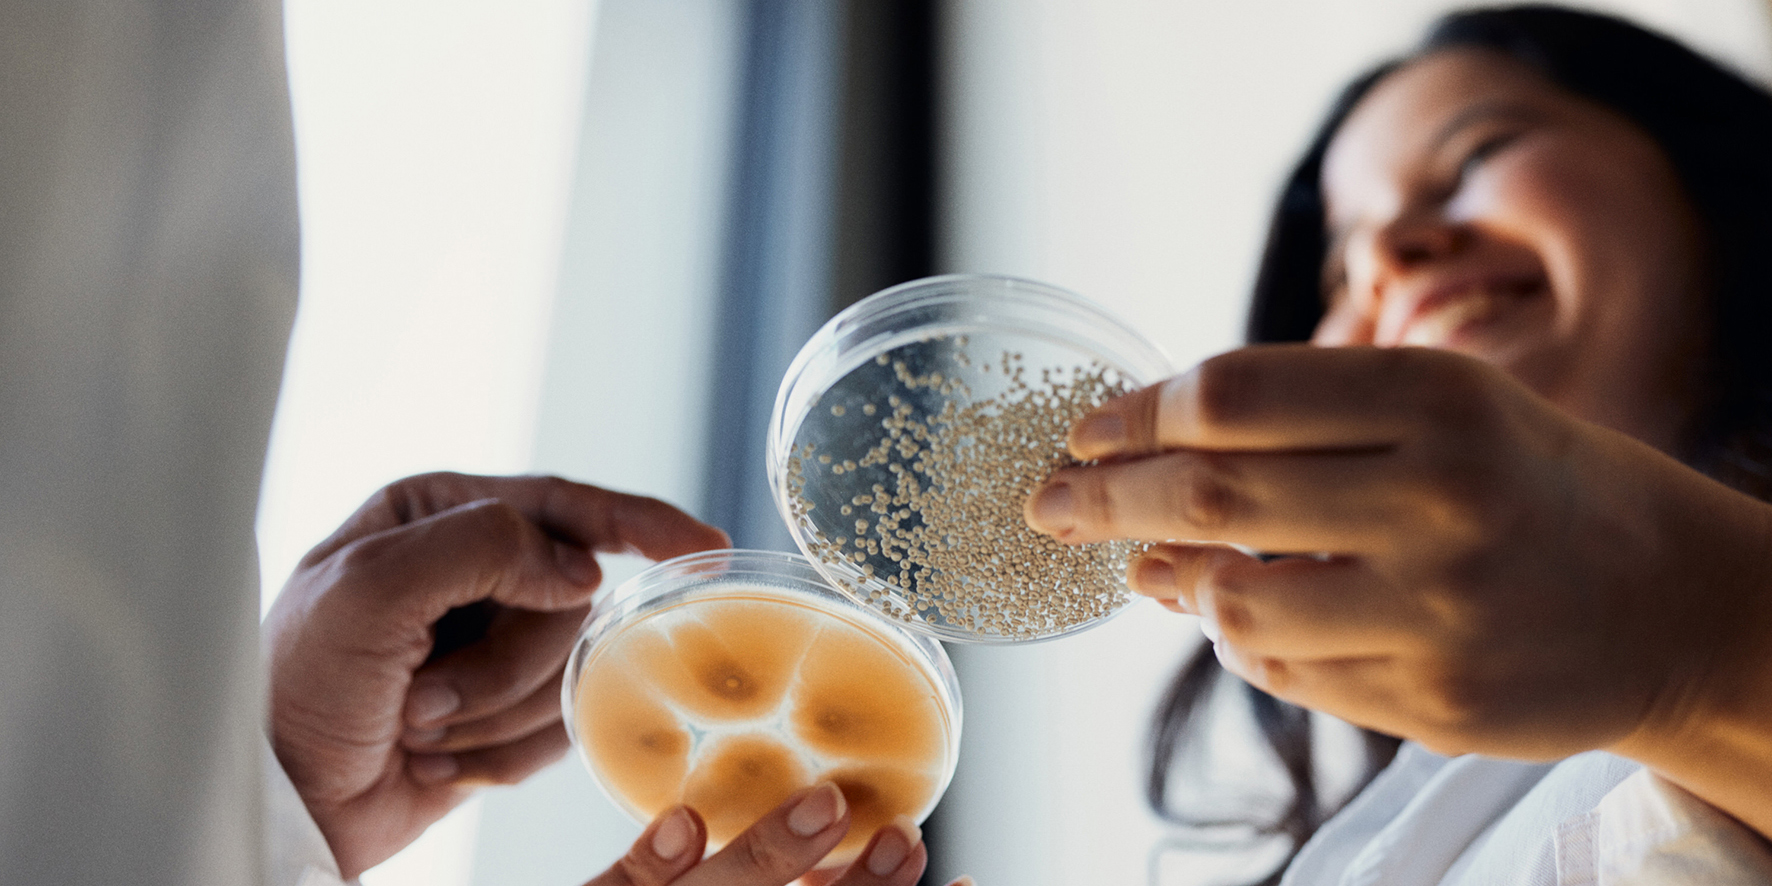

- Home
-
Hochschule
- Aktuelles
-
Profil
- Zahlen, Daten, Fakten
- Selbstverständnis der HSBI
- Qualitätsverständnis
- Leitbild Lehre
- Lehrpreis
- Netzwerk Innovatives Lehren und Lernen (InnoLL)
- Prozessmanagement
- Familiengerechte Hochschule
- Diversity
- Weltoffene Hochschule
- Strategie Internationales
- Nachhaltigkeit
- Rückblick: 50 Jahre FH Bielefeld
- Feedback
- Fachbereiche
- Zentrale Organisation
- Standorte / Anfahrt
- HSBI-Portale
-
Studium
- Studienangebote
-
Beratung
- Studienorientierung
- Zentrale Studienberatung
- Studienfachberatung
- Psychosoziale Beratung
- Studienfinanzierung und Stipendien
- Schreibberatung
- Studieren mit beruflicher Qualifikation
- Studieren mit ausländischen Zeugnissen
- Studieren mit Handicap
- Studieren mit Familie
- Informationen für Schulen
- Auslandsaufenthalt
-
Bewerbung
- Auswahlgrenzen und Vergabeverfahren (NC)
- Bewerbungsportal
- Bewerbung Schritt für Schritt: Von der Bewerbung bis zur Einschreibung
- Bewerbung für ein höheres Fachsemester
- Bewerbung mit beruflicher Qualifikation
- Jungstudierende
- Gasthörerschaft und Zweithörerschaft
- Kontakt Studierendenservice
- Losverfahren
- Promotion
- Sonderanträge
- Studiengang wählen
- Wer kann an der HSBI studieren?
- Studienstart
-
Studium organisieren
- Studierendenservice
- Abschlussunterlagen
- Anerkennung von Leistungen
- Anträge einreichen
- Beurlaubung
- CampusCard
- Einreichung schriftliche Arbeiten
- Erstattung
- Exmatrikulation
- IT-Services
- Online-Serviceportale (LSF/CAT)
- Prüfungsangelegenheiten: Ordnungen, Modulhandbücher
- Rücktritt von einer Modulprüfung
- Rückmeldung
- Semesterbeitrag
- Semesterticket (Deutschlandsemesterticket)
- Semester-, Vorlesungs- und Prüfungszeiten
- Studienbezogene Auslandserfahrung
- Vorlesungsverzeichnis
- Rund ums Studium
- Fachbereiche
- Forschung
- Transfer
- Weiterbildung
- Internationales
- Karriere an der HSBI
HSBI-Promovendin erhält DPG-Preis 2023 für ihre Arbeit über einen Pilz als Pflanzenschutzmittel
Linda Muskat hat den Nachwuchspreis der Deutschen Phytomedizinischen Gesellschaft e.V. für ihre Doktorarbeit über den Pilz Pandora erhalten. Die Biologin, die ihre Forschungen an der HSBI durchführte und mittlerweile eine Professur an der Hochschule Geisenheim besetzt, arbeitet zur Frage, wie das Gewächs als vollständig biologisch abbaubares Pflanzenschutzmittel einsetzbar ist. Übergeben wurde Preis auf der 63. Deutschen Pflanzenschutztagung, die noch bis zum 29. September 2023 in Göttingen stattfindet.
Bielefeld (hsbi) Er ist ein Pilz, der wissenschaftlich noch gar nicht vollständig beschrieben ist. Sein Name: Pandora cacopsyllae. Mit ihm geht Prof. Dr. Linda Muskat gegen Blattflöhe vor, die die tückische Apfeltriebsucht übertragen. Diese Krankheit kann in Apfelplantagen verheerende Schäden anrichten, und deswegen zahlt Muskat es den Blattflöhen gleichsam mit gleicher Münze heim: Sie lässt die Insekten ihrerseits mit den für sie giftigen Pilzsporen infizieren, sodass den schädlichen Krabblern der Garaus gemacht wird.
Von alledem handelt die Doktorarbeit, die Muskat kooperativ an der Hochschule Bielefeld (HSBI) mit der Bestnote summa cum laude abgeschlossen hat und die ihr gleich im Anschluss eine Professur an der Hochschule Geisenheim einbrachte. Auf ihren Forschungen beruhen zudem zwei Patentanmeldungen, die sie mit der HSBI getätigt hat. Damit nicht genug: Nun ist die Biologin auch noch mit dem Nachwuchspreis der Deutschen Phytomedizinischen Gesellschaft e.V. geehrt worden. Die Gesellschaft hält dieser Tage die 63. Deutsche Pflanzenschutztagung in Göttingen ab, die größte und wichtigste Phytomedizin-Konferenz im deutschsprachigen Raum, zu der Teilnehmende aus Wissenschaft und Industrie zusammenkommen.
Schlaue „Attract-and-kill-Strategie“ gegen Schadinsekten, die Apfeltriebsucht übertragen

Muskat hält auf der Tagung zwei Postervorträge. In denen präsentiert sie die wichtigsten Ergebnisse ihrer Doktorarbeit. Außerdem geht es bei den Postervorträgen um die Perspektiven ihrer Forschungen. Der für Laien schwer verständliche Titel von Poster 1 lautet „Oleogele – eine neue Formulierungsmatrix für Semiochemikalien“. Formulierung – das bedeutet in diesem Zusammenhang die Überführung eines Wirkstoffes in eine anwendbare Form. Das Poster beschreibt eine spezielle Formulierung, die auf den gefährdeten Apfelbäumen gut haftet und schädliche Insekten anlockt, um sie zu einer zweiten Formulierung zu führen, durch die das Insekt dann getötet wird.
Davon handelt Poster 2: Muskat legt hier dar, wie eine Paste den lebenden und für Insekten giftigen Pilz Pandora ausreichend feucht hält, damit dieser seine Infektionseinheiten auch unter sommerlichen Bedingungen im Apfelhain – das ist dann, wenn auch die Blattflöhe aktiv sind – in ausreichenden Mengen ausschleudern und damit die Schadinsekten infizieren kann. Der Name Pandora ist also Programm: „Man spricht von einer Attract-and-kill-Strategie“, so Muskat. Das Gute daran: Die Pilzsporen haben auf die die Insekten zwar fatale Wirkung, sind in ihrer Wirkung auf die übrige Umwelt jedoch unbedenklich.
Kooperation mit Kollegin aus São Paulo: Einsatz in Zuckerrohrfeldern denkbar

Das zweite Poster trägt den Titel „Technical aspects of above-ground applications of entomophthoralean fungi for insect pest control” und ist gleichzeitig ein gemeinsames Poster mit der HSBI-Gastdoktorandin Daniela Milanez Silva von der Universidade de São Paulo in Brasilien. Silva arbeitet ebenfalls daran, einen neuen insektenabtötenden Pilz nutzbar zu machen, der vielleicht künftig in brasilianischen Zuckerrohrfeldern als biologisches Pflanzenschutzmittel zum Einsatz kommen kann. Der Name des Pilzes lautet Batkoa, und er ist nah verwandt mit Muskats Pandora. Da lag es nahe, dass Silva während ihres Forschungsaufenthalts an der HSBI sich gemeinsam mit Muskat mit der Trocknungs- und Lagerfähigkeit des Pilzes beschäftigte und verschiedene Trocknungsverfahren ausprobierte.
Muskat startet nun an der Hochschule Geisenheim durch: Sie genießt den freien Gestaltungsspielraum, den ihr die dortige sogenannte Tenure-Track-Professur bietet. Das ist eine „Professorin in Ausbildung“-Stelle, in der die junge Wissenschaftlerin an ihre neue Position herangeführt wird und mit einem stark reduzierten Lehrdeputat einsteigt. Mit Unterstützung der dortigen Personalentwicklungsabteilung bildet sie sich weiter in den Bereichen Führung und Didaktik. In der Lehre hat sie bereits erste Vorlesungen im Studiengang Gartenbau übernommen. „Als nächstes kommen weitere Vorlesungen, Seminare und Praktika hinzu, auf die ich mich besonders freue, da ich hier sozusagen freie Hand habe und selber neue Kursinhalte einbringen und gestalten darf“, erzählt Muskat. Fachlich sind die Module alle im Bereich der Phytopathologie und dem Pflanzenschutz in den Bachelor- und Master-Studiengängen Weinbau und Gartenbau angesiedelt. Thematisch soll die Lehre eng an der aktuellen Forschung anknüpfen. Vielleicht arbeitet dann die eine oder andere Studierendengruppe von Prof. Muskat alsbald mit einem weiteren nutzbringendem Pilz… (lk)
Wer mehr über die Arbeit und den Hintergrund von Prof. Dr. Linda Muskat erfahren möchte, sei auf unsere Geschichte anlässlich des Abschlusses ihres Promotionsstudiums hingewiesen: Zur Pressemitteilung
Bielefelder Institut für Angewandte Materialforschung (BIfAM)